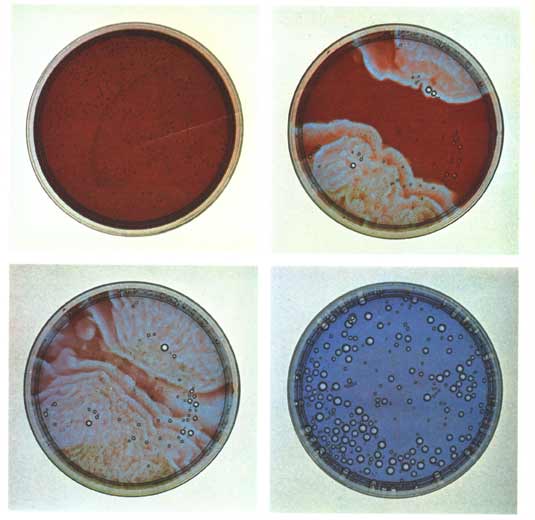

1970 entdeckten Zhabotinsky und A. N. Zaikin, daß neben periodischen Farbumschlägen der ganzen Lösung bei einer geringfügig geänderten Zusammensetzung der Mischungen auch Farbumschläge in begrenzten Gebieten auftreten, die sich als „chemische Wellen" mit spiralförmigen Wellenfronten in der Lösung ausbreiten.
Ich möchte einige Rezepte für chemische Oszillatoren angeben und beschreiben, wie sich chemische Wellen erzeugen und beobachten lassen. Schließlich werde ich, soweit man die Vorgänge heute versteht, auch erklären, wie die periodischen Farbumschläge zustande kommen.
Zeitlich oszillierende Reaktionen
Die Einwaage der Substanzen erfordert keine allzu große Sorgfalt, da geringfügige Abweichungen bei den Konzentrationen der Bestandteile die Farbumschläge nicht beeinträchtigen. Allerdings müssen Sie mit sauberen Gefäßen arbeiten und dürfen Ihre Finger nicht in die Lösung tauchen; Verunreinigungen, besonders von der Haut gelöste Chloride, könnten die Oszillationen verhindern. Aus dem gleichen Grund empfiehlt es sich auch, das Natriumbromat vor dem Gebrauch zu reinigen. Dazu löst man möglichst viel Bromat in heißem Wasser, das sich in einem wärmeisolierten Gefäß befindet. Die Wärmeisolierung erreicht man am besten, indem man den Behälter in Styropor verpackt. Das zugedeckte oder verschlossene Gefäß läßt man ein bis zwei Wochen ruhig stehen; danach wird die überstehende Lösung abgegossen, und das auskristallisierte Bromat mit einem sauberen Spatel ausgekratzt. Beim Umgang mit Natriumbromat ist ebenfalls Vorsicht geboten; es ist ein starkes Oxidationsmittel und darf nicht in die Nähe offener Flammen kommen.
Die chemischen Reaktionen, die die Farbumschläge auslösen, sind recht kompliziert. Bild 2 gibt eine vereinfachte Darstellung. In der Lösung reagiert das Natriumbromat mit dem Natriumbromid, und das dabei gebildete Brom wandelt die Malonsäure in Brommalonsäure um. Das Bromat-Ion würde auch mit dem Ferroin reagieren und dem in ihm enthaltenen, zweifach positiv geladenen Eisen ein Elektron entziehen (es zum dreifach positiv geladenen Eisen oxidieren), wenn es durch die Bromid-Ionen nicht daran gehindert würde. Solange das Eisen zwei positive Ladungen trägt, ist Ferroin rot gefärbt, nach der Elektronenabgabe dagegen blau. Die Farbe der Lösung sollte demnach von rot nach blau umschlagen, sobald die Bromid-Ionen verschwinden. Dieser Fall tritt ein, wenn durch die Umsetzung mit der Malonsäure praktisch alles Bromid verbraucht ist. Die blaue Farbe der Lösung ist jedoch nicht stabil, weil nun die Brommalonsäure anfängt, das blaue Eisen(III)-Ferroin zu rotem Eisen(II)-Ferroin zu reduzieren, wobei das Eisen ein Elektron zurückerhält. Dabei bildet sich wieder Bromid, das wie anfangs den roten Zustand vorübergehend stabilisiert. Bald ist das Bromid allerdings durch die Umsetzung mit der Malonsäure erneut aufgebraucht, so daß ein neuer Zyklus beginnt. Die Farbumschläge lassen sich etwa eine Stunde lang beobachten, bis das Bromat oder die Malonsäure aufgebraucht ist. Je nachdem, welche dieser Substanzen zu Beginn in der höheren Konzentration vorlag, bleibt die Lösung dann blau oder rot.

Diesem wird von der Brommalonsäure ein Elektron zurückgegeben, so daß es erneut in rotes Eisen(ll)-Ferroin übergeht. Da bei dieser Reakti
on auch Bromid zurückgebildet wird, kann der Kreislauf von vorn beginnen.
Bei der Normalität berücksichtigt man, daß bestimmte chemische Stoffe, zum Beispiel Säuren und Basen, in wäßriger Lösung in geladene Teilchen (Ionen) zerfallen (dissoziieren). Tragen diese Tonen alle nur eine (negative oder positive) Ladung, ist die Normalität der Lösung gleich der Molarität. Trägt eine Ionensorte jedoch zwei oder drei Ladungen, ist die Normalität zwei- oder dreimal so hoch wie die Molarität. Mit anderen Worten: Die Normalität ist gleich der Molarität, multipliziert mit der Ladung, die das höchstgeladene Ion, das bei der Dissoziation der Moleküle entsteht, trägt. So enthält beispielsweise ein Liter einer 1-molaren Schwefelsäure 98 Gramm H2SO4 (das Molekulargewicht der Schwefelsäure ist 98); sie ist 2-normal, weil die Sulfat-Ionen so42-, in die sie dissoziiert, zweifach negativ geladen sind.
Doch nun zu den Varianten von Winfree's Grundrezept. Zunächst einmal kann man das Natriumbromid ganz weglassen, da es im Verlauf der Reaktion bei der Reduktion des Eisen(III)-Ferroins durch die Brommalonsäure von selbst entsteht. Ohne Bromid angesetzte Oszillatoren schwingen schneller, weil in den einzelnen Perioden weniger Bromid aufgebraucht werden muß. Weiterhin läßt sich ein Teil des Ferroins durch soviel Cer(IV)-sulfat ersetzen, daß die entstehende Lösung 0,1-molar an Cersulfat ist. Schließlich kann die Schwefelsäure gegen eine harmlosere wäßrige Lösung von Natriumhydrogensulfat und die Malonsäure gegen Zitronen- oder Maleinsäure ausgetauscht werden. Bei Ihren Experimenten können Sie generell die Konzentrationen der einzelnen Bestandteile und die Temperatur verändern und beobachten, wie dies die Periode des Oszillators beeinflußt.

Die „Iod-Uhr" ist ein besonders einfacher und billiger chemischer Oszillator mit einem Farbumschlag von farblos über goldgelb nach blau. Um ihn zu erproben, benötigen Sie drei Lösungen. Stellen Sie sich zunächst eine 3,6-molare Wasserstoffperoxid-Lösung her, indem Sie zu sechzig Millilitern Wasser vierzig Milliliter 30-prozentiges Wasserstoffperoxid hinzufügen. (Gehen Sie mit dem Wasserstoffperoxid äußerst vorsichtig um, da es auf der Hand schmerzende Verätzungen hervorruft!) Lösen Sie in einem zweiten Gefäß 4,3 Gramm Kaliumiodat in hundert Millilitern Wasser und säuern Sie die Lösung mit 2,3 Millilitern konzentrierter (70-prozentiger) Perchlorsäure an. (Die Perchlorsäure ist gleichfalls ätzend und brennt Löcher in Kleider, Holz und Kunststoff.) Damit sich das Kaliumiodat vollständig auflöst, müssen Sie die Lösung vermutlich etwas erwärmen. Geben Sie in das dritte,Gefäß 1,5 Gramm Malonsäure, O,3 Gramm Mangan(II)-sulfat und dreißig Milligramm Stärke und fügen Sie hundert Milliliter Wasser hinzu. Nun brauchen Sie nur noch gleiche Teile der drei Lösungen zusammenzugießen, um die erwähnten Farbumschläge zu beobachten. Die blaue Farbe entsteht bei der IodUhr dadurch, daß während der Reaktion vorübergehend gebildetes Iod mit der Stärke den bekannten blauen Iod-Stärke-Komplex ergibt. Acetylaceton (2,4Pentandion) anstelle der Malonsäure oder Cer(III)-sulfat anstelle des Mangansulfats führen zu kürzeren Schwingungsperioden.
Chemische Wellen
Ich habe schon erwähnt, daß es nötig ist, die Lösung eines chemischen Oszillators umzurühren (am besten mit einem Magnetrührer), damit die Farbe überall gleichzeitig umschlägt. Andererseits können sich in der unbewegten Lösung manchmal farbige Wellenfronten bilden, die sich von einzelnen Punkten aus in Form von Kreisen, Ellipsen oder Spiralen mit Geschwindigkeiten von einigen Millimetern pro Minute ausbreiten (Bild 3) und ihrerseits faszinierende Studienobjekte darstellen.
Die Wellenfronten treten besonders deutlich in Erscheinung, wenn man in Winfree's Grundrezept den Bromidanteil erhöht und gleichzeitig den Anteil der Schwefelsäure verringert, indem man beispielsweise der Natriumbromatlösung nur einen (statt zwei) Milliliter konzentrierte Schwefelsäure zusetzt. Außerdem empfiehlt Winfree, die fertige Lösung nur etwa einen Milliliter hoch in eine Petrischale aus Kunststoff zu gießen. Die Schale muß besonders sauber sein, weil an Schmutzteilchen und Kratzern bevorzugt Kohlensäurebläschen aufsteigen, von denen dann zu viele Wellen ausgehen. Wenn Sie die Schale mit der Reaktionslösung auf eine zweite Schale stellen, die mit einer blauen Kupfersulfatlösung und einigen Tropfen Schwefelsäure gefüllt ist, und beide Schalen von unten durchleuchten, so tritt der Farbkontrast der Wellenfronten besonders deutlich in Erscheinung. Zusätzlich absorbiert die Kupfersulfatlösung die von der Lichtquelle ausgesandte Wärmestrahlung, die sonst in der oberen Schale Konvektionsströmungen hervorrufen und die Ausbreitung der Wellenfronten stören könnte. Außerdem sollten Sie die Petrischale mit einem Uhrglas zudecken, damit der Luftzug keine Strömungen auslösen kann und die Flüssigkeit nicht zu schnell eintrocknet. Wenn sich in der ruhig stehenden Schale nach einigen Minuten noch keine Wellenfront gebildet hat, müssen Sie die Lösung mit einer heißen Nadel berühren und so künstlich eine
Welle auslosen. In der Regel sind aber genügend Blasen, Kratzer oder Staubteilchen vorhanden, von denen Wellen ausgehen konnen.
Die Vermutung liegt nahe, daß die zeitlichen Oszillationen und die chemischen Wellen auf ähnlichen chemischen Reaktionen beruhen. Während normalerweise das Bromid überall in der Losung gleichmäßig mit Bromat und Malonsaure reagiert, kann ein Gasbläschen, ein Kratzer oder eine heiße Nadelspitze die Reaktion örtlich beschleunigen. Dadurch wird das Bromid an dieser Stelle verbraucht, während in der Umgebung noch Genügend davon vorhanden ist. Das hat zwei Konsequenzen: Einmal schlagt die Farbe des Ferroins an der Stelle, die kein Bromid mehr enthält, von Rot nach Blau um. Zum anderen diffundiert aus der Umgebung Bromid zur Störstelle, an der das Bromid aufgebraucht ist. Dadurch verarmt die Umgebung an Bromid, so daß auch hier das Ferroin durch Bromat oxidiert wird und sich blau färbt. Somit breitet sich eine blaue Wellenfront in der Losung aus. In ihrer Ausbreitungsrichtung ist sie schmal, weil
die blaue Farbe an ihrer Ruckseite recht schnell verschwindet, wenn sich aus Brommalonsaure und blauem Ferroin wieder Bromid und rotes Ferroin zuruckbilden. Daß es sich um chemische und nicht die üblichen hydrodynamischen Wellen handelt, erhellt daraus, daß die Flüssigkeit selbst in Ruhe ist. Im Unterschied zu den üblichen Wellen (Wasser-, Schall-, Lichtwellen) werden die chemischen Wellen auch nicht an Hindernissen oder der GefaBwand reflektiert. Ebensowenig überlagern oder
durchdringen sie sich gegenseitig: stattdessen löschen sie sich grundsätzlich aus, wenn sie aufeinandertreffen. Beide Erscheinungen (Auslöschung und fehlende Reflexion) sind in Bild 3 deutlich zu erkennen.

Ist die Flüssigkeit tief genug, so daß die Höhe des Zylinders im Zentrum der Spirale größer ist als der Durchmesser des Zylinders, sind noch andere Orientierungen der Zylinderachse möglich, die zu unterschiedlichen Wellenformen führen (Bild 4). Ist die Achse zum Beispiel geneigt, so entsteht an der Oberfläche eine elliptisch verzerrte Spirale. Der Zylinder im Zentrum kann auch gebogen sein und etwa ein auf dem Kopf stehendes U bilden. Von oben sieht man dann Ringsysteme, die zu Kreisen entarten, wenn der Bogen des U die Oberfläche gerade berührt. Auf der Unterseite erscheint eine spiegelsymmetrische „Zwillingsspirale". Bildet der Zylinder einen waagrecht liegenden Ring, so erscheinen an der Oberfläche konzentrische Kreise, von denen der innere nach innen, der äußere nach außen wandert.
Vielleicht wollen Sie ausprobieren, wie sich Hindernisse, die Sie den chemischen Wellen in den Weg stellen, auf das Wellenmuster auswirken. Damit keine hydrodynamischen Wellen entstehen, wenn Sie das Hindernis in die Flüssigkeit einbringen, sollte die Lösung sehr zäh sein. Das erreichen Sie, indem Sie die Flüssigkeit mit dem doppelten Volumen kolloidaler Kieselsäure zu einer salbenähnlichen Masse vermischen.

Anstatt die Wellen zu photographieren, kann man das Momentbild einer Wellenfront auch auf dem Filter „einfrieren" und konservieren. Das gelingt nur, wenn das Filter nicht in ÖL aufbewahrt wurde. Sobald ein Muster entstanden ist, das Ihnen gefällt, können Sie die Plastikfolien entfernen und das Filter fünf Minuten lang in eine eisgekühlte, gesättigte Kochsalzlösung tauchen. Nach dieser Zeit sind alle Salze mit Ausnahme des roten Eisen(II)-Ferroins aus den Filterporen herausdiffundiert. Das Filter wird danach mit Löschpapier getrocknet, kurz in eine Natriumiodidlösung (ein Gramm Natriumiodid auf vierzig Milliliter Wasser) getaucht, wieder mit Löschpapier abgetrocknet und zehn Minuten lang in ein Gefäß gehängt, in dem sich einige Iodkörner befinden. Dabei fixieren die von den Körnern aufsteigenden Ioddämpfe das Ferroin im Filter. Abspülen mit destilliertem Wasser, Trocknen an der Luft und Schwimmen auf Paraffinöl reinigt das Filter vollends. Zwischen selbstklebenden, durchsichtigen Plastikfolien bleibt das Muster der Wellenfronten auf dem Filter nun jahrelang erhalten und büßt nichts von seiner Schärfe ein. Um die Wellen für einen Tag zu konservieren, genügt es, das Filter kurz in eisgekühlte 3-prozentige Perchlorsäure zu tauchen. Das Muster wird dabei allerdings etwas verwischt und verschwindet, wenn das Filter austrocknet.
Mit Hilfe mehrerer Filter, die Sie übereinander in die Reaktionslösung legen, können Sie aus den ebenen Wellenmustern, die sich in unterschiedlicher Höhe bilden, auch die räumliche Verteilung der Wellen rekonstruieren. Lassen Sie die Filter solange in der Lösung, bis sich auf dem obersten ein Wellenmuster gebildet hat. Warten Sie aber nicht länger als nötig (höchstens fünf Minuten), sonst lösen die entstehenden Kohlensäurebläschen die Filter voneinander ab. Holen Sie den Filterstapel als Ganzes aus der Lösung und „fixieren" Sie die einzelnen Filter, wie oben beschrieben, möglichst gleichzeitig. Wenn Sie anschließend die Mittelpunkte der Spiralen auf jedem Filter ausmessen, können Sie feststellen, ob die zu den Spiralen gehörenden Zylinder senkrecht oder schräg zur Oberfläche standen oder gebogen waren, und damit eine Vorstellung von der räumlichen Verteilung der Wellen gewinnen.
Welche Wellen sich im Filterstapel bilden, muß nicht dem Zufall überlassen werden. Eine räumliche Welle, bei der (Bild 4, ganz unten rechts) der Zylinder im Zentrum der Spirale zu einem waagrecht liegenden Torus gebogen ist, läßt sich in einem Filterstapel auf folgende Weise herstellen: Nehmen Sie einen Stapel aus fünf Filtern, die mit frisch bereiteter Reaktionslösung getränkt sind, und erzeugen Sie eine zylindrische Welle, indem Sie die Mitte des obersten Filters mit der Spitze einer heißen Nadel berühren. Legen Sie auf diesen Stapel, sobald sich der erste Wellenring gebildet hat, einen zweiten Stapel aus fünf Filtern, die gleichfalls mit frischer Reaktionslösung getränkt sind. Der Ring auf dem ersten Stapel wird nun im zweiten Stapel Wellen der geschilderten Art erzeugen. Nach einer Weile erscheint auf dem obersten Filter des zweiten Stapels ein blauer Kreis, aus dem sich zwei kreisförmige Wellen lösen, wobei die eine nach innen, die andere nach außen läuft (Bild 4, ganz unten links).
Man kann Filter so präparieren, daß sich jederzeit ohne großen Aufwand chemische Wellen auf ihnen erzeugen lassen. Dazu mischt man zehn Milliliter einer 1-molaren Lösung des Ammoniumsalzes der Brommalonsäure mit der gleichen Menge einer 0,025-molaren Ferroin-Losung und zwanzig Millilitern einer 4-molaren Lösung von Ammoniumhydrogensulfat (sechsundvierzig Gramm auf hundert Milliliter). Ein Membranfilter wird mit dieser Lösung benetzt und auf einer Kunststoffunterlage getrocknet. Nehmen Sie nun ein Papierfilter, tränken Sie es mit 0,33-molarer Natriumbromat-Lösung (fünf Gramm Natriumbromat auf hundert Milliliter Wasser) und lassen Sie es ebenfalls trocknen. Beide Filter sind unbegrenzt haltbar. Wenn Sie die chemischen Wellen vorführen wollen, feuchten Sie das Papierfilter an, breiten es in einer sauberen Petrischale aus Plastik aus und bedecken es mit dem Membranfilter. Nach wenigen Minuten werden auf dem Filter blaue Punkte erscheinen, von denen Wellenringe ausgehen, die sich mit einer Geschwindigkeit von wenigen Millimetern pro Sekunde ausbreiten.
Arthur T. Winfree, Institute for Natural Philosophy, 51 Knoll Crest Court, West Lafayette, Ind. 47906 (USA), verschickt präparierte Membranfilter. Wenn Sie ihm vier Dollar und einen international freigemachten Antwortumschlag mit Ihrer Adresse senden, erhalten Sie von ihm ein knapp hundert Quadratzentimeter großes Filter, das Sie nur noch anfeuchten müssen, um chemische Wellen auszulösen, die sich dreißig Minuten lang beobachten lassen. Die von Winfree präparierten Filter können Sie erwärmen, kühlen, zerschneiden, mit einer heißen Nadel oder einer Rasierklinge berühren und stapeln, um die beschriebenen Erscheinungen nachzuvoIlziehen oder Ihre eigenen Experimente zu machen.
Physikalisch-chemischer Hintergrund
Kann eine gleichmäßig durchmischte (homogene) Lösung bei konstanter Temperatur und konstantem Druck plötzlich ihre Farbe, ihre chemische Zusammensetzung, ihre elektrische Leitfähigkeit oder sonst eine physikalische Eigenschaft periodisch ändern? Diese Frage hat die Chemiker seit dem letzten Jahrhundert beschäftigt, und die Antwort ist auch heute noch umstritten. Zwar bezweifelt niemand, daß sich in abgeschlossenen, inhomogenen (uneinheitlichen) Systemen, in denen Dichte- und Konzentrationsunterschiede herrschen, Schwingungen ausbilden können (abgeschlossene Systeme können im Gegensatz zu offenen Systemen weder Materie noch Energie mit der Umgebung austauschen) und dasselbe gilt für offene Systeme, denen kontinuierlich Substanzen von außen zugeführt werden; einige wenige Chemiker meinen aber auch heute noch, daß Schwingungen in abgeschlossenen, homogenen Systemen wie den hier betrachteten nicht vorkommen dürfen
Um dieses Problem zu verstehen, wollen wir zunächst die Frage klären, unter welchen Bedingungen Stoffe miteinander reagieren. Reaktionen laufen meistens dann ab, wenn dabei Wärme frei wird. Diese Wärme bezeichnet man als Enthalpie der Reaktion. Vor allem bei hohen Temperaturen laufen jedoch auch Reaktionen ab, die Wärme verbrauchen. Hier ist der Grund für das Auftreten der Reaktion, daß die Atome oder Moleküle in einen weniger geordneten Zustand übergehen: die Unordnung oder Entropie nimmt zu. Enthalpie und Entropie lassen sich zu einer neuen Größe zusammenfassen. Sie heißt freie Enthalpie, und ihr Wert entscheidet darüber, ob Stoffe miteinander reagieren oder nicht. Eine Reaktion wird immer dann stattfinden, wenn sich die freie Enthalpie der Reaktionspartner dabei verringert. Die Reaktion wird aufhören, sobald die freie Enthalpie den kleinstmöglichen Wert erreicht hat. Das chemische System, das durch die verschiedenen Reaktionspartner und Reaktionsprodukte gebildet wird, befindet sich dann im Gleichgewicht.
Auf den ersten Blick scheinen die oszillierenden Reaktionen diesen wohlfundierten Prinzipien zu widersprechen, denn bei ihnen läuft die Reaktion ja anscheinend im ständigen Wechsel sowohl vorwärts wie rückwärts ab. Die freie Enthalpie kann aber nicht in beiden Richtungen zugleich abnehmen. Man kann es auch so ausdrücken: Das System der Reaktionspartner und -produkte scheint um den Gleichgewichtszustand zu schwingen, was nach dem zweiten Hauptsatz der Thermodynamik verboten ist.
Genau hier liegt jedoch der Trugschluß. Das System ist nämlich weit vom Gleichgewicht entfernt. Die Reaktionsschritte, die zwischen zwei Farbumschlägen liegen, verbrauchen jeweils nur einen ganz kleinen Teil der Reaktionspartner Natriumbromat und Malonsäure und machen folglich nur einen kleinen Teil der Gesamtreaktion aus. Die Konzentration des Bromids nimmt zwar periodisch zu und ab (womit letztlich die Farbumschläge zusammenhängen), aber die Konzentration der Reaktionspartner Natriumbromat und Malonsäure schwankt nicht, sondern verringert sich kontinuierlich. Die Gesamtreaktion schreitet also in einer Richtung fort, wie das vom zweiten Hauptsatz der Thermodynamik gefordert wird. Sie tut das vermittels zweier Teilreaktionen' die in ständigem Wechsel einsetzen und wieder zum Erliegen kommen. Auch die beiden Teilreaktionen laufen, wie wir gesehen haben, jeweils nur immer in einer Richtung ab und lediglich die Tatsache, daß die Farbe Rot im Verlauf der zweiten Teilreaktion zurückgebildet wird, erzeugt den falschen Eindruck, daß die zweite Teilreaktion die Umkehrung der ersten sei. Insofern ist auch der Begriff oszillierende Reaktion irreführend. Ist ein großer Teil der Reaktionspartner Natriumbromat und Malonsäure verbraucht, und nähert sich das chemische System dem Gleichgewicht, hören die Oszillationen auf, und die Lösung verhält sich „normal".
Damit ein chemisches System oszilliert, muß eine Teilreaktion sich selbst beschleunigen oder hemmen. Anschaulich kann man sich diesen Vorgang als Rückkopplung vorstellen. Es wurden Modelle für oszillierende chemische Systeme aufgestellt, die diese Rückkopplungen einbeziehen, und mit denen sich die Oszillationen rechnerisch simulieren lassen. Die entsprechenden Gleichungssysteme sind allerdings sehr kompliziert, und in vielen Fällen sind die genauen Vorgänge noch nicht geklärt.
Oszillierende Reaktionen dürften bei biologischen Prozessen eine wichtige Rolle spielen. So nimmt man an, daß die biologische Uhr, die zum Beispiel den Tag-Nacht-Rhytmus steuert, auf chemischen Oszillationen beruht.
Zum Schluß noch ein Wort zu den benötigten Chemikalien. Sie sind alle in den Katalogen der großen Chemie-Firmen zu finden. Zunächst können Sie versuchen, sie in Ihrer Apotheke zu bestellen. Wenn dies nicht möglich ist, müssen Sie sich an eine Chemikalien-Großhandlung wenden.